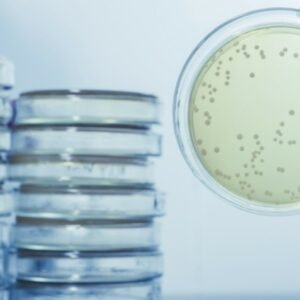
Basic Legionella Management

Emergency First Aid at Work

Course overview
The Astutis CDM 2015 in Practice course provides an in-depth explanation of the Construction (Design and Management) Regulations 2015. It covers the specific interactive duties the regulations place on those planning, managing and monitoring construction activities. Learners will have the sufficient knowledge to assist in achieving compliance with these regulations.
This course is suitable for those involved in planning, managing or undertaking construction activities. The course also offers those new to CDM an introduction to the 2015 Regulations to help them understand their legal responsibilities.
Did you know? At Astutis, our course prices include everything: from the training itself, first sitting of the assessments, certification and should you need it a free assessment resit. We provide an all-inclusive training package with no hidden costs, just real value!
Introduction to CDM 2015 and interpretation of scope, application and key terminology.
Clients’ new duties and responsibilities
The specific and practical interactive duties of planning, managing and coordinating between the five key duty holders.
Overview of the general health and safety requirements for all construction sites.
Key Documentation: Notification, Preconstruction Information, Construction Phase Plan, Health and Safety File.
£20.00
why this course is good for you!
The Astutis CDM 2015 in Practice course provides an in-depth explanation of the Construction (Design and Management) Regulations 2015. It covers the specific interactive duties the regulations place on those planning, managing and monitoring construction activities. Learners will have the sufficient knowledge to assist in achieving compliance with these regulations.
This course is suitable for those involved in planning, managing or undertaking construction activities. The course also offers those new to CDM an introduction to the 2015 Regulations to help them understand their legal responsibilities.
Did you know? At Astutis, our course prices include everything: from the training itself, first sitting of the assessments, certification and should you need it a free assessment resit. We provide an all-inclusive training package with no hidden costs, just real value!

Reviews
There are no reviews yet.